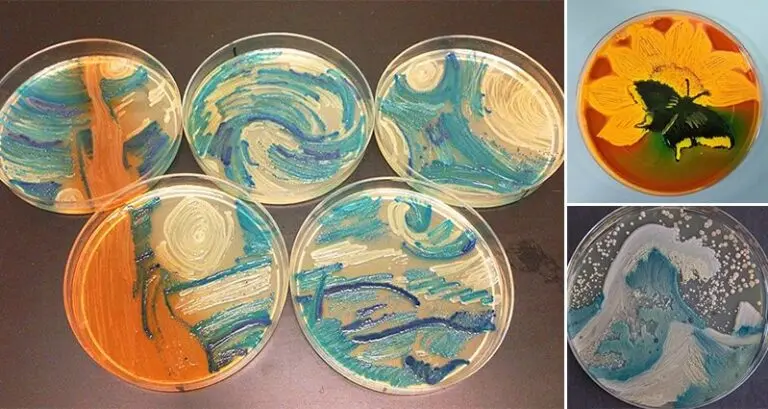
Bacteria International Agar Art Challenge

We've seen art made from some pretty unusual materials, but this might be the strangest. The 'American Society for Microbiologists' hosted its very first annual 'International Agar Art Challenge' in 2015, which saw entrants from around the world send in art that they'd created using bacteria. One of the entrants recreated Van Gogh's 'Starry Night' from various bacteria (Proteus mirabilis, Acinetobacter baumanii, Enterococcus faecalis and Klebsiella pneumonia to be precise), and it's actually fairly accurate! We've got photos of more entries too, though the rest mostly went for original art. How it works is that scientists create an agar plate in a Petri dish, on which they can grow bacteria. Different bacteria have different colors, so by strategic placing and guiding the bacteria, they can create art! Let's take a look!
Website: American Society for Microbiologists










Pretty neat! We wouldn't recommend amateurs trying this at home, though, unless they want to unleash some sort of super bacteria on the world. It's probably best sticking to paint!
Source: 1